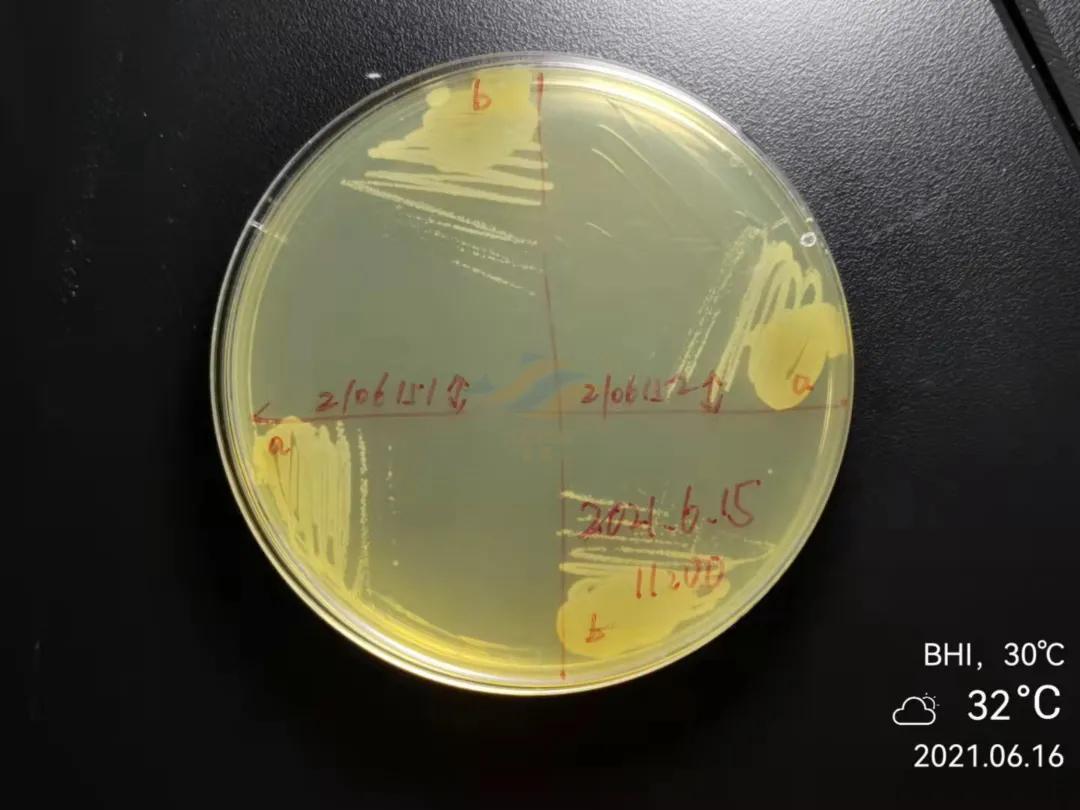
鱼得了肠炎还能活多久,生鱼烂身治疗
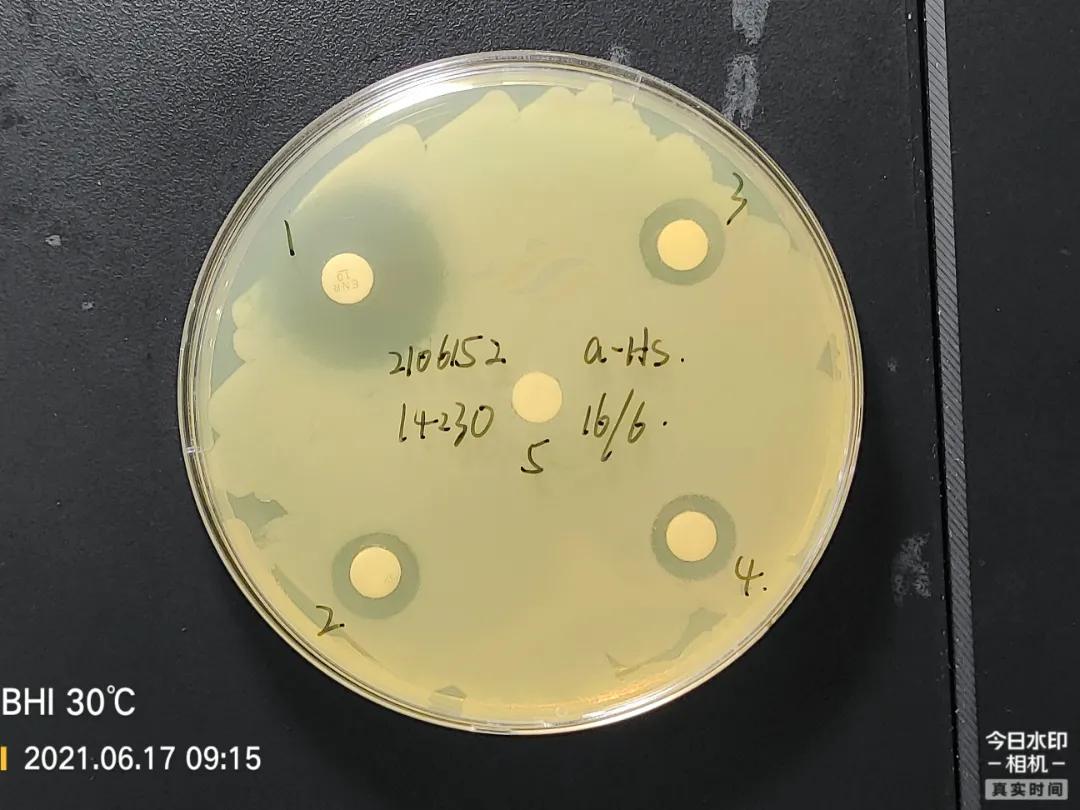
鱼得了肠炎还能活多久,生鱼烂身治疗

作者 | 梁芝源 胡飞 陈斯若 胡雄 活宝源鱼病室
鱼病的病原-----病毒、细菌、真菌、寄生虫等的生物学特性差异极大,其对药物的敏感性千差万别,治疗思路与用药方案完全不同。
即使是生命力极顽强、以“浮头三天不死”而著称的生鱼(乌鳢、杂交鳢),在每年炎热的夏季也饱受舒伯特气单胞菌病、诺卡氏菌病等细菌性病害的肆虐。
尽管“以防为主,防重于治,防治结合”是鱼病防控工作的方针,业内关于鱼病预防的理论、策略、产品(方案)不枚胜举,但是,养殖一线的细菌病依然年年流行,每年都有大量养殖户因之遭受惨重的损失。在气势汹涌的鱼类细菌病面前,我们该怎么办呢?
本文基于一个典型案例谈谈对鱼类细菌病诊治的认识与思考,希望对大家有所帮助,欢迎评论区的小伙伴留下您的见解!
一、病情概况
2021年6月 ,广东广州,某养殖场有6口池塘,全部养殖生鱼(杂交鳢),其基本信息如下:
|
塘号 |
水面 |
水深 |
存塘数量 |
存塘重量 |
|
1# |
7亩 |
2米 |
6万尾 |
12万斤 |
|
2# |
7亩 |
2米 |
4万尾 |
8万斤 |
|
3# |
4亩 |
2米 |
2.5万尾 |
5万斤 |
|
4# |
4亩 |
2米 |
3万尾 |
4.5万斤 |
|
5# |
11亩 |
2米 |
12万尾 |
15.6万斤 |
|
6# |
11亩 |
2米 |
7万尾 |
13.5万斤 |
5月15日 ,该养殖场个别鱼塘开始出现死鱼,症状表现为花身、内脏有白点(结节)。
5月20日, 塘主采集病鱼送至活宝源鱼病室进行检测,经诊断为舒伯特气单胞菌病,遵建议连续用药3天,未见明显效果,塘主改用胆汁酸、三黄类中药调理。
5月30日, 死鱼进一步增多,其他池塘也开始发病。
6月1日, 塘主送病鱼到附近药店检测,被诊断为诺卡氏菌病,并开具了诺卡氏套餐进行治疗,拌药4天,死鱼不减反增,日损耗增至300余尾。塘主又送病鱼到另一家药店检测,被诊断为弹状病毒病,遂采取停料、换水、解毒抗应激等措施进行处理,至6月15日病情仍未见好转,再次采样送至活宝源鱼病室进行全面检测。
二、实验室检测
塘主仅送检病情较为严重的 1#塘(编号2106151) 和 5#塘(编号2106152)。
外观上,病鱼体表有少量斑点状或针尖状出血灶,活力很弱(P01,02);鳃丝基本红润,未见明显异常(P03);解剖,可见肝脏、脾脏、肾脏等处有大量细小白点(结节)(P04~06);胃、肠明显充血发红(P07)。


■ P01,02 示病鱼体表少量斑点状/针尖状出血灶


■ 左:P03 示病鱼鳃丝红润;右:P04 示肝脏白点


■ 左:P05 示脾脏细小白点;右:P06 示肾脏细小白点;

■ P07 示肠道明显发红;
依次剪取适量鳃丝和刮取体表病灶粘液制成水浸片,光学显微镜下观察,未见 寄生虫或诺卡氏菌菌体(P08) 。无菌操作,取病鱼肾脏组织接种于脑心浸液琼脂培养基,30℃恒温培养24h,均有大量圆形、细小、浅黄灰色、 湿润菌落(P09) ;取其进行革兰氏染色,镜检,菌体呈短杆状、 显红色(阴性)(P10) ;结合经验,初步判断为舒伯特气单胞菌;将其纯化后进行药敏试验(纸片法),结果显示,2个菌株均对1号抗菌药高度敏感,对氟苯尼考、强力霉素等其它常见 渔用抗生素高度耐药(P11,12)。

■ P08 鳃丝未见寄生虫

■ 左:P09 示内脏培养到大量细菌;右:P10 示革兰氏染色后的菌体形态

■ P11,12 示药敏试验
|
菌株/抗菌药 |
抑菌圈(φ,cm) |
|||||
|
编号 |
1 |
2 |
3 |
4 |
5 |
|
|
2106151 |
b-S |
2.5 |
1.3 |
1.2 |
1.15 |
0 |
|
2106152 |
a-S |
2.5 |
1.15 |
1.2 |
1.15 |
0 |
三、治疗方案与效果
结合实验室检测和诊治经验,初步判断接检的2塘生鱼均为舒伯特气单胞菌病。经交流,塘主表示其6口塘的病情和症状均高度相似,故建议其全部按舒伯特气单胞菌病进行治疗。考虑到塘主在换水后已进行水体消毒,故建议其选用敏感抗生素(1号抗生素)搭配维生素K3等拌料投喂即可。
6月20日上午,塘主反馈,其使用上述内服方案已4天,死鱼量不减反增,从开始拌药时的161尾/天增至200尾/天,准备放弃治疗。经沟通分析发现,该养殖场拌药时的投喂量严重偏低,总损耗量确略有增加,但是,其中1#塘、2#塘的4日平均投喂率均低于0.25%,死鱼数量不降反增;而3#、4#、5#塘的4日平均投喂率略高,达0.46%~0.60%之间,病情则维持稳定或略有好转。


■ 图13,14塘主记录的日常投喂和损耗数据






■ 图15~20,基于图13~14的数据分析,可见,投喂率较高的池塘有明显疗效。
经反复沟通,在再三要求下,塘主同意继续用药4天(适当加量用药)。6月30日,塘主反馈,遵建议继续用药后,死鱼迅速减少,除了投喂率严重偏低的1#塘尚有11条死鱼外,其余5口塘损耗基本清零,客户对方案疗效十分认可!






四、对鱼类细菌病诊治的认识与思考
引发鱼病的因素可分为生物性病原和非生物性病原两大类,前者又可分为病毒、细菌、真菌、寄生虫等。根据相关监测统计,由细菌感染引起的鱼病所占比例最高,达45%左右。珠三角地区气候温热,几乎全年均有细菌病流行,给水产养殖业带来巨大的威胁;即使是生命力极顽强、以“浮头三天不死”而著称的生鱼(乌鳢、杂交鳢),在每年炎热的夏季也饱受舒伯特气单胞菌病、诺卡氏菌病等细菌性病害的肆虐。尽管“以防为主,防重于治,防治结合”是鱼病防控工作的方针,业内关于鱼病预防的理论、策略、产品(方案)不枚胜举,但是,养殖一线的细菌病依然年年流行,每年都有大量养殖户因之遭受惨重的损失。在气势汹涌的鱼类细菌病面前,我们该怎么办呢?结合本案例,回顾多年的鱼病诊治经验,笔者认为有以下几点。
4.1 准确诊断是前提
鱼病的病原-----病毒、细菌、真菌、寄生虫等的生物学特性差异极大,其对药物的敏感性千差万别,治疗思路与用药方案完全不同。比如,对于病毒病,无有效治疗药物,应以减缓应激以及使用温和型消毒剂进行水体消毒,以阻止病情进一步恶化,尽量减少损失;对于细菌病,则需通过选用高效的消毒剂以及内服拌喂敏感抗生素进行治疗;而对于体表性寄生虫病,则需以水体杀虫为主。准确诊断,尤其是准确判断主要病原的种类,选择正确的处理思路,是有效治疗的前提。如本案例,塘主在前期盲目停料、换水,或按弹状病毒病的思路进行处理,均未获得明显疗效,病情反而逐渐进一步恶化。
对于大部分细菌病而言,仅根据外观症状以及显微镜等工具很难准确判断,需要进行细菌分离培养方可确诊。
4.2 选对药、选好药是关键
鱼类致病细菌的种类十分丰富,不同种类的病原菌对药物的敏感性差异很大;即使是同一种细菌,受地域、用药史等影响,对药物的敏感性会出现重大分化。进行细菌分离培养,通过纸片法药敏试验筛选出敏感抗生素,并通过试管法测定其有效抑菌浓度和有效杀菌浓度,对于治疗具有十分关键的指导作用。比如,鰤鱼诺卡氏菌和舒伯特气单胞菌都会引起生鱼的肝脏、脾脏、肾脏等出现白点(结节),但二者对常见渔用抗生素的敏感性差异极大,大部分鰤鱼诺卡氏菌对强力霉素较为敏感,而多数舒伯特气单胞菌则对强力霉素高度耐药,本案例中,塘主也拌过所谓的诺卡氏菌套餐,但并未能控制病情。进行致病菌分离和药敏试验,筛选敏感抗生素,可以大大提高治疗的成功率。
其次,选对药物种类的同时,选好药物的质量也十分重要。虽然可以通过药敏试验筛选出敏感抗生素及测定有效抑菌浓度,但由于业内进行药敏试验所使用的药敏片、抗生素原粉均为标准品或需标准品标定,其质量远非市面廉价的劣质药、“三无”产品可比。我们建议,即使是做了药敏试验,也应选用质量可靠的国标药。
4.3 用药方案的彻底执行是保障
准确诊断,选对药,选好药,距离治疗细菌病的成功已经完成了九十九步,但还差一步,很容易被忽视的一步,那就是对用药方案的彻底执行。一方面,鱼病发生的原因十分复杂,有的鱼病很难治疗,有的鱼病有多种方案,没有任何一个渔医能100%治好鱼病,很多养殖户并没有百分百信任渔医;另一方面,对于很多养殖户而言,养殖事关一年的收成,当遭遇重大病害时,容易着急、恐慌,进而乱用药、盲目用药;再者,近年来,一些厂家借推广养殖技术之名,行推销自家产品之实,散布了大量东拼西凑的、错误的病害防控知识,干扰了养殖户的认知,等等。由于这些影响,养殖户在执行渔医开具的用药处方时往往会不够彻底或擅自变更,使疗效大打折扣。正如本案例,5月中旬该病害已经被我们鱼病室准确诊断为舒伯特气单胞菌病,但塘主仅用药3天便放弃而转用其它方案,最终拖了一个月,试遍各种治疗方案,最终才重新找到我们诊断;塘主第二次使用我司方案治疗第4天,未见损耗明显减少,又想放弃处理,经我们收集其资料进行细致的分析后,塘主仍信心不足,要求减量用药,经反复沟通,塘主才愿严格按我司要求执行治疗方案,最终才获得良好疗效,有效控制了病情。
鱼病的诊治是一项对经验和技术要求都非常高的工作,除上述提到的三点外,天气、水质、底质、投喂等很多因素也会对疗效产生巨大的影响。总体而言,鱼类大部分细菌病都可以治愈,且通过细菌培养和药敏试验可以大大提高治疗成功率。笔者认为,一名优秀的渔医,应时刻保持学习,合理应用专业仪器设备,提高诊断能力,筛选有效药物,提高开具处方的有效性;也应勤总结,哪些鱼病能治好,几天可以治好,哪些鱼病很难治,怎样降低损失,不断积累经验,提高对疗效的预判能力,增强客户的信心;在开具处方时,需将疗效放在首要位置,必要时拒绝养殖户的某些不合理要求,并与养殖户充分沟通,确保方案得到彻底的执行。当然,作为养殖户,也要加强养殖知识的学习,学会辨别一些错误的“知识”,相信科学,相信专业。科学的治疗方案彻底得到执行时,细菌病才能快速得到控制,而这,需要渔医和养殖户共同的努力。